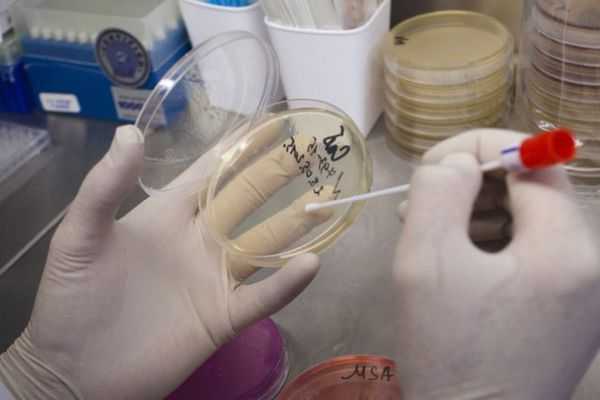
bak_pos.jpg

Зачем нужен гинекологический мазок на флору и где его сдать: Инвитро и другие лаборатории
Мазок на флору — это методика обследования, предполагающая, что врач берет небольшое количество материала со слизистой, который исследуется на предмет наличия бактерий и микроорганизмов, являющихся возбудителями заболеваний мужских и женских половых органов. Такое название он носит, поскольку с его помощью врач может оценить состояние микрофлоры половой системы.
Мазок на флору — основной анализ, с помощью которого оценивается состояние микрофлоры мочеполовой системы
Исследование выполняется по назначению гинеколога или уролога (у мужчин). Показаниями к нему являются следующие факторы:
- жжение в области половых органов;
- зуд;
- боли и дискомфортные ощущения внизу живота;
- выделения;
- кровотечение;
- планирование беременности.
У женщины мазок берется в гинекологическом кресле специальным шпателем, которым материал для исследования наносится на стекло. В урологии применяется зонд, с помощью которого делается соскоб из уретры. Глубина его введения – не более трех сантиметров, поскольку именно на этом участке скапливаются бактерии.
Для того чтобы подготовиться к исследованию, рекомендуется:
- за 24 часа воздержаться от половых контактов;
- не употреблять накануне сдачи алкоголь;
- не принимать ванну;
- не пользоваться свечами и влагалищными таблетками;
- за два часа не мочиться.
Сдать гинекологический и урологический мазок можно как в специализированной клинике, так и в лаборатории, при условии, что в ней оборудован кабинет гинеколога.
Планируя исследование во время беременности, стоит уточнить в выбранной лаборатории, делает ли она такой анализ. Многие из них берут мазок только до определенного срока – как правило, до 18-20 недель.
- Лаборатории Инвитро. Стоимость анализа составляет 550 руб., взятие материала – 400 р.
- Гемотест. Цена исследования – 440 р., взятие материала – 400 р.
- ЦИР. Исследование стоит 430 руб. (без учета забора). Цена экспресс-анализа (от одного часа) – 860 р. Цены будут ниже, если оформлять оплату через Интернет.
- Поколение NEXT. Цена без забора материала – 260 р., для мужчин – 150 рублей. Есть возможность взять материал из одной точки (уретра, влагалище или шейка) за 150 р.
- Он-Клиник. Стоимость с учетом забора составляет 650 рублей.
- Кроме того, сдать анализ бесплатно можно в любой женской консультации: он входит в разряд базовых, которые делаются, в том числе, и в государственных районных медицинских учреждениях.
На результаты мазка могут влиять многие факторы – например, беременность у женщин, прием антибиотиков и другие. Кроме того, методика обработки, используемое оборудование и критерии оценки могут отличаться в разных лабораториях, поэтому подробной расшифровкой анализа должен заниматься врач.
до 30до 5Превышение нормального уровня свидетельствует о воспалении
отклонений
беременности – до 20)
Нередко значения на бланке обозначаются не словами, а знаками « »
- — в незначительном количестве;
- — умеренно;
- — количество увеличено;
- — обильно.
Сегодня брала мазок на флору в гемотесте, и вот при вытаскивании зеркала Медсестра умудрилась меня прищемить. Ужас! Это больно и до сих пор жутко неприятно, жалко себя((( но я задумалась: а это не опасно? У кого-нибудь вообще такое бывало или я одна такая?
На втором скрининге узистка сказала что утолщена немного плацента, надо бы провериться на инфекции. Сдала вчера обычный мазок на флору в жк и мазок на инфекции методом пцр в гемотесте. Результат из гемотеста не совсем сама разобрала, отправила подруге гинекологу. Она мне сказала что все в норме,чуть повышен Candida albicans,то бишь грибок вызывающий молочницу.
Врачи отмечают, что урологический мазок на флору является важным диагностическим инструментом в урологии. Он позволяет выявить наличие патогенных микроорганизмов, что особенно актуально при подозрении на инфекции мочеполовой системы. Специалисты подчеркивают, что данный анализ помогает не только в диагностике, но и в выборе адекватной терапии, что способствует более эффективному лечению пациентов.
Кроме того, врачи рекомендуют проводить этот тест регулярно, особенно при наличии симптомов, таких как боль при мочеиспускании или выделения. Своевременное выявление инфекции может предотвратить развитие осложнений и улучшить качество жизни пациента. В целом, урологический мазок на флору является неотъемлемой частью комплексного подхода к диагностике и лечению заболеваний мочеполовой системы.
Гемотест урологический мазок на флору вызывает разнообразные отзывы среди пациентов. Многие отмечают, что процедура достаточно быстрая и не вызывает сильного дискомфорта. Люди ценят высокую точность анализа, что позволяет своевременно выявить возможные инфекции и воспалительные процессы. Некоторые пациенты подчеркивают важность консультации с врачом после получения результатов, так как это помогает правильно интерпретировать данные и выбрать оптимальное лечение. Однако встречаются и негативные мнения, связанные с длительным ожиданием результатов и недостаточной информативностью по поводу дальнейших действий. В целом, большинство пользователей рекомендуют этот анализ как важный шаг в диагностике урологических заболеваний.
https://youtube.com/watch?v=3OCKsvf-tuY
Вопрос-ответ
Что такое урологический мазок на флору?
Урологический мазок — лабораторный метод обследования, с помощью которого проводится исследование отделяемого уретры на микрофлору и клеточный состав. Анализ является базовым и проводится всем мужчинам при первичном обращении к урологу или венерологу.

Какие болезни может показать мазок на флору?
Воспалительные процессы органов репродуктивной системы, Разрастание плоского эпителия, Злокачественные новообразования, Заболевания, передаваемые половы путем, Грибковые инфекции, Дисплазия матки и шейки матки.
Что является ограничением по взятию гинекологических мазков гемотест?
Ограничения к взятию материала: возраст моложе 18 лет, девственность (вне зависимости от возраста), беременность с 31-й недели, угроза прерывания беременности на любом сроке.

Как подготовиться к сдаче мазка на микрофлору?
Как подготовиться к сдаче мазка на флору Потребуется: воздержаться на 1–2 суток от половых контактов, не применять вагинальные препараты (крема, свечи) и не делать спринцевания в течение 2 суток, перед сдачей мазка на флору рекомендуется не мочиться в течение 2–3 часов.
Советы
СОВЕТ №1
Перед сдачей урологического мазка на флору рекомендуется воздержаться от половых контактов за 24-48 часов. Это поможет избежать искажения результатов анализа и повысит их точность.
СОВЕТ №2
Обязательно проконсультируйтесь с врачом перед проведением анализа. Он сможет дать рекомендации по подготовке к исследованию и объяснить, какие факторы могут повлиять на результаты.
СОВЕТ №3
Следите за гигиеной перед сдачей мазка. Убедитесь, что область гениталий чистая, но избегайте использования мыла или антисептиков, которые могут повлиять на флору и результаты анализа.
СОВЕТ №4
После получения результатов анализа не спешите делать выводы самостоятельно. Обсудите их с врачом, который сможет правильно интерпретировать данные и назначить необходимое лечение при необходимости.